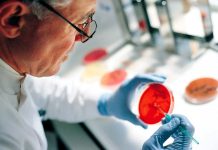
Разработанный учеными препарат от рака прямой кишки показал 100% эффективность

Нострадамус и его пророчества: что ждет мир в 2025 году?
Несмотря на то, что с момента смерти знаменитого французского астролога Мишеля де Нострадамуса прошло уже 458 лет, его предсказания продолжают волновать умы людей по...
Разработанный учеными препарат от рака прямой кишки показал 100% эффективность
Препарат для лечения рака прямой кишки Достарлимаб, также известный под торговой маркой Jemperli, получил статус «Прорыв в терапии» от Управления по санитарному надзору за...
Ученые создали модуль ИИ, способный несколько месяцев работать от батарейки-таблетки
Компания Ambient Scientific анонсировала новый модуль искусственного интеллекта под названием Sparsh, который работает от батарейки-таблетки и предназначен для использования в различных приложениях на устройствах....
Ученые обнаружили у сердца сложную нервную систему
Недавнее исследование, проведенное учеными из Каролинского института в Швеции и Колумбийского университета в США, обнаружило сложную нервную систему, охватывающую сердце рыбок данио, что ставит...
Путешествия во времени: Что происходит с памятью и реальностью?
Представьте, что вам предлагают уникальную возможность отправиться в прошлое, увидеть события, которые изменили ход истории, или встретиться с великими умами прошлого. Но есть одно...
Билл Гейтс: «Искусственный интеллект хорош, но есть нюансы»
Соучредитель и бывший глава Microsoft Билл Гейтс недавно поделился своими мыслями об искусственном интеллекте в подкасте Armchair Expert с Даксом Шепардом. Несмотря на то,...
«Не думай о розовом слоне»: как афантазия меняет восприятие мыслей
Если бы вы услышали фразу «не думай о розовом слоне», вряд ли смогли бы избежать визуализации этого абсурдного образа. Однако новое исследование, проведенное профессором...
В Сеуле открылось кафе, где каждый час идет дождь
Представьте себе кафе, где каждые 15 минут начинается дождь. Именно такую концепцию воплотило в жизнь новое заведение Rain Report Cafe, расположенное в одном из...
Учёные предупреждают об опасности создания зеркальной жизни
Группа ведущих учёных призывает общество серьёзно обсудить риски, связанные с созданием форм жизни, основанных на так называемых «зеркальных молекулах». Эти необычные существа пока ещё...
Искусственный интеллект теперь понимает язык растений
Впервые ИИ смог научиться читать и интерпретировать генетический код растений так же, как ChatGPT разбирается в человеческих языках. Исследователи...
Является ли наша Вселенная фракталом? Что думают ученые
На протяжении многих десятилетий астрономы и физики размышляли: является ли структура Вселенной фрактальной? То есть, сохраняется ли её облик независимо от того, на каком...
Ученые, возможно, нашли истинное назначение Стоунхенджа
Исследователи выдвинули гипотезу, что знаменитый Стоунхендж, помимо своей духовной и астрономической значимости, мог выполнять ещё одну важную функцию — символизировать объединение различных племён и...
Загадочные «недозвёзды»: коричневые карлики — космические странники
Коричневые карлики — это своего рода «недозвезды». Они обладают массой, превышающей массу крупнейших газовых гигантов вроде Юпитера, но всё же недостаточно массивны, чтобы стать...
На дне Балтийского моря обнаружили мегаструктуру длиной 1 километр
На дне Балтийского моря, в Мекленбургском заливе, исследователи обнаружили древнюю стену, простирающуюся почти на километр. Это может быть старейшей известной мегаструктурой, построенной людьми в...
Древний папирус может содержать сведения о встрече египтян с НЛО, считают исследователи
Обнаруженный исследователями папирус Тулли взволновал историков и уфологов. Считается, что документ, который на самом деле не является папирусом, содержит свидетельства первого в истории наблюдения...
Зависимость от телефона: Когда привычка становится проблемой
Сегодня многие из нас уже не представляют своей жизни без мобильных устройств. Мы постоянно проверяем уведомления, листаем ленты социальных сетей и используем гаджеты буквально...
Ученые создали технологию на основе алмазов, способную в 1000 раз усилить сигналы из космоса
Когда речь идет о драгоценностях, мало кто задумывается об их роли в науке. Однако группа ученых из Университета Нового Южного Уэльса (UNSW) перевернула представление...
Эксперты предупреждают: солнечный максимум — это только начало!
Эксперты по космической погоде встревожены: солнечная активность, которая только что официально вошла в фазу солнечного максимума, может не только сохраниться, но и значительно усилиться....
Перевернутая чёрная дыра: загадка древней галактики
В начале 2024 года астрономы NASA заявили о том, что впервые была обнаружена галактика, чья сверхмассивная чёрная дыра вращается вопреки привычным законам космоса. Что...
Как ядро нашей планеты влияет на продолжительность суток
Земля, казалось бы, вращается с идеальной точностью, обеспечивая стабильный цикл смен дня и ночи длиной ровно в 24 часа. Однако эта точность лишь иллюзия....
Фарфоровая посуда: преимущества и особенности
Фарфоровая посуда — это не просто утилитарные предметы для сервировки стола, но и настоящие произведения искусства, которые придают особое очарование любому приему пищи. Высококачественная...
Неожиданное открытие: высотки Майами тонут быстрее, чем ожидалось
Недавние исследования показали, что 35 роскошных высоток на побережье Майами-Бич (США) тонут в воде значительно быстрее, чем ранее предполагали эксперты. Это открытие стало тревожным...
Загадочный незнакомец провоцирует ДТП и помогает жертвам
В Небраске (США) ведется расследование загадочного инцидента, связанного со странным мужчиной, которого подозревают в организации нескольких автомобильных аварий. По словам полиции, этот человек не...